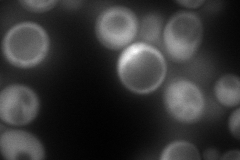
YPR062W
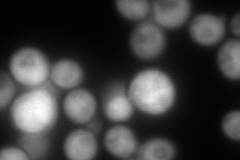
YPR062W
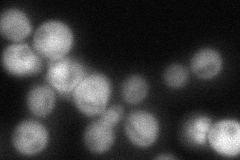
YPR062W
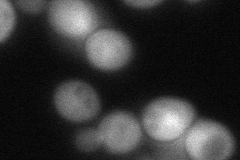
YPR062W

View description
Cytosine deaminase, zinc metalloenzyme that catalyzes the hydrolytic deamination of cytosine to uracil; of biomedical interest because it also catalyzes the deamination of 5-fluorocytosine (5FC) to form anticancer drug 5-fluorouracil (5FU)
Localization:
Intensity:
Fold change:
Significance:
-
C’ GFP library in SD

below threshold17.17 -
N' NOP1pr-GFP in SD
cytosol179.395 -
N' TEF2pr-mCherry in SD
cytosol291.765 -
N' NATIVEpr-GFP in SD
cytosol73.3466 -
N' TEF2pr-VC and Cyto-VN in SD
cytosol73.1792 -
C’ GFP library in SD+DTT

cytosol15.650.91No -
C’ GFP library in SD+H2O2

cytosol17.110.99No -
C’ GFP library in Starvation Media

cytosol17.811.03No -
C’ GFP library on the background of Pup2-DaMP

below threshold -
C’ GFP library on the background of CCT mutant

below threshold16.27560.94719No
